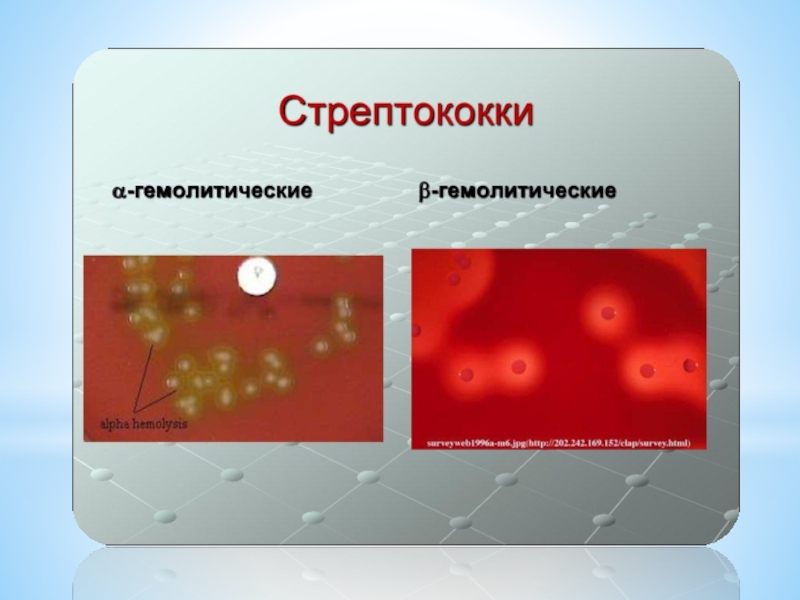

Разделы презентаций
- Разное
- Английский язык
- Астрономия
- Алгебра
- Биология
- География
- Геометрия
- Детские презентации
- Информатика
- История
- Литература
- Математика
- Медицина
- Менеджмент
- Музыка
- МХК
- Немецкий язык
- ОБЖ
- Обществознание
- Окружающий мир
- Педагогика
- Русский язык
- Технология
- Физика
- Философия
- Химия
- Шаблоны, картинки для презентаций
- Экология
- Экономика
- Юриспруденция
Частное учреждение образовательная организация высшего образования "Медицинский
Содержание
- 1. Частное учреждение образовательная организация высшего образования "Медицинский
- 2. Стрептококк (лат. Streptococcus) – это бактерия шарообразной или яйцеподобной формы, принадлежащая к семейству Стрептококковые (Streptococcaceae)
- 3. Стрептококки являются анаэробными паразитами не только человека,
- 4. Виды стрептококковВсего известно около 100 видов стрептококков,
- 5. Альфа-гемолитические стрептококки:Streptococcus pneumoniae (Пневмококк). Является основным возбудителем
- 6. Альфа-гемолитические стрептококки:
- 7. Streptococcus thermophilus (Стрептококк термофильный). Синонимы: Streptococcus salivarius
- 8. Streptococcus mutans (Стрептококк мутанс). Способствует развитию таких
- 9. Streptococcus sanguis (ранее — Streptococcus sanguis). Является
- 10. Бета-гемолитические стрептококкиБета-гемолитические стрептококки обычно несут в себе
- 11. Серогруппа B (GBS): Streptococcus agalactiae. Эта группа
- 12. Слайд 12
- 13. Слайд 13
- 14. Заболевания, которые способны вызвать стрептококкиАбсцесс, флегмоны;Бронхит;Васкулит;Гломерулонефрит;Импетиго;Лимфаденит;Менингит;Остеомиелит;Острый тонзиллит (ангина);Пародонтит;Пневмония;
- 15. РевматизмРожистое воспаление (рожа);Сепсис;Скарлатина;Стрептодермия;Фарингит;Хейлит, заеды;Эндокардит;Заболевания мочеполовой системы.
- 16. Слайд 16
- 17. Слайд 17
- 18. ИммунитетПосле перенесенных стрептококковых инфекций остается антибактериальный иммунитет,
- 19. Слайд 19
- 20. Слайд 20
- 21. Слайд 21
- 22. Скачать презентанцию
Слайды и текст этой презентации
Слайд 1Частное учреждение образовательная организация высшего образования "Медицинский университет "Реавиз«
Слайд 2Стрептококк (лат. Streptococcus) – это бактерия шарообразной или яйцеподобной формы,
принадлежащая к семейству Стрептококковые (Streptococcaceae)
Слайд 3Стрептококки являются анаэробными паразитами не только человека, но и животных.
Местом обитания и размножения стрептококковой инфекции являются органы дыхания, желудочно-кишечного
тракта и мочеполовой системы мужчин и женщин, может находиться на коже. Преобладающее же количество бактерий стрептококк обычно оседает в носу, ротовой полости, горле и толстом кишечнике, иногда встречается в уретре мужского органа и влагалище женщиныСлайд 4Виды стрептококков
Всего известно около 100 видов стрептококков, каждый из которых
характеризуется своей патогенностью.
Для удобства, данный род бактерий, в зависимости от
типа гемолиза эритроцитов, выделили в 3 основные группы (классификация Брауна):Альфа-стрептококки (α), или зеленящие стрептококки — вызывают неполный гемолиз;
Бета-стрептококки (β) — вызывают полный гемолиз, и являются наиболее патогенными бактериями;
Гамма-стрептококки (γ) – являются негемолитическими бактериями, т.е. они не вызывают гемолиза.
Слайд 5Альфа-гемолитические стрептококки:
Streptococcus pneumoniae (Пневмококк). Является основным возбудителем таких болезней, как
– пневмония (воспаление легких), менингит, бронхит, ларингит, средний отит, ринит,
остеомилит, септический артрит, перитонит, эндокардит, сепсис и другие. Место оседания – дыхательные пути человекаСлайд 7Streptococcus thermophilus (Стрептококк термофильный). Синонимы: Streptococcus salivarius thermophilus, Streptococcus salivarius
subsp. thermophilus. Является полезной бактерией. Используется для приготовления полезных молочных
продуктов – йогуртов, сметаны, ряженки, различных сыров (например – моцареллы), используется в БАДах.Слайд 8Streptococcus mutans (Стрептококк мутанс). Способствует развитию таких заболеваний, как –
кариес зубов. Развитие кариеса из-за данной вида бактерии происходит из-за
ее свойства переводить сахарозу, глюкозу, фруктозу и лактозу в молочную кислоту, благодаря которой происходит постепенной разрушение зубной эмали. Streptococcus mutans имеет также свойство прилипать к зубной эмали, поэтому тщательная чистка зубов и полоскание ротовой полости специальными средствами являются профилактической мерой против данного вида инфекции.Streptococcus salivarius (Слюнной стрептококк). Обычно обитает в ротовой полости и верхних дыхательных путях человека – в носу, в горле. Как и предыдущий тип, Streptococcus salivarius способен ферментировать сахарозу в молочную кислоту, однако не имеет такой же патогенности, как первый. В современном мире, некоторые штаммы слюнного стрептококка используют в качестве пробиотика. Его используют для производства специальных сосательных леденцов, способных предохранять полость рта с более опасными типами стрептококков. Замечено, что присутствие в полости рта слюнного стрептококка способствует снижению риска заразиться ангиной, фарингитом и другими инфекционными болезнями верхних дыхательных путей.
Слайд 9Streptococcus sanguis (ранее — Streptococcus sanguis). Является обычным обитателем зубного
налета, однако имеет интересное свойство – он предотвращает прилипание к
зубам streptococcus mutans, косвенно способствующего развитию кариеса.Streptococcus mitis (ранее — Streptococcus mitior). Обычно оседают в верхних дыхательных путях – носовой и ротовой полости, горле. Этот вид бактерии является одним из возбудителей такого заболевания сердца, как — инфекционный эндокардит.
Слайд 10Бета-гемолитические стрептококки
Бета-гемолитические стрептококки обычно несут в себе наибольшую опасность для
здоровья человека. Это связано с их способность разрушать эритроциты (красные
кровяные тельца). При этом во время своей жизнедеятельности, бета-стрептококки выделяют большое количество различных токсинов (ядов), распространение по организму которых приводит к различным сложным, а иногда и смертельно-опасным болезням и патологическим состоянияСлайд 11Серогруппа B (GBS): Streptococcus agalactiae. Эта группа стрептококков обычно оседает
в кишечнике и мочеполовой системе. Способствуют развитие различных инфекционных заболеваний
новорожденных детей и рожениц – эндометрита, менингита, сепсиса, неврологические расстройства и другие.Серогруппа A (GAS): Streptococcus pyogenes (ранее — Streptococcus haemolyticus), Streptococcus agalactiae anginosus, S. dysgalactiae subsp. Еquisimilis. Эта группа стрептококков обычно способствует развитию большого количества болезней по всему организму — ангины, фарингита, пиодермии, скарлатины, вагинита, цистита, цервицита, эндометрита и других.